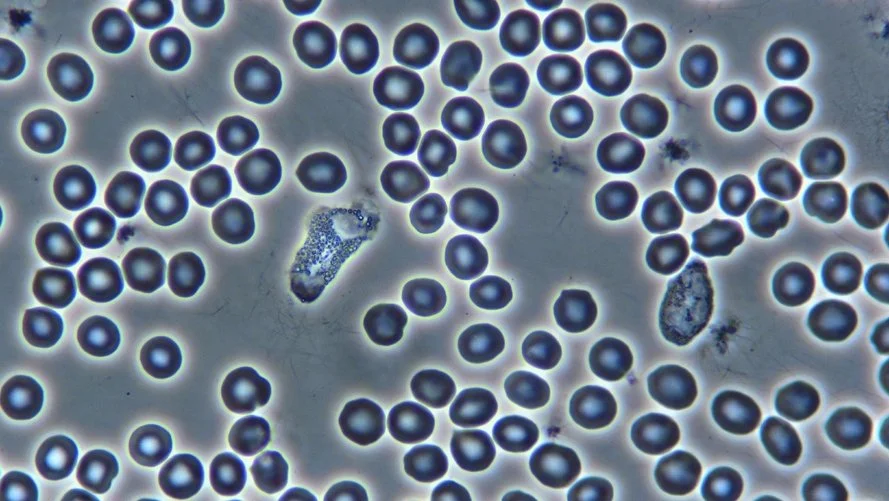

Services & Offerings
Welcome to Mind+Body Synergy, where we offer comprehensive, holistic health solutions designed to optimize your mental and physical well-being. Our approach integrates mind, body, and biochemical balance to address the root causes of health issues.

Explore our range of services to discover how we can help you achieve lasting wellness. Click on each picture below to learn more about our offerings and begin your journey to optimal health!
COMING SOON — Live Blood Analysis

COMING SOON —Integrative Muscle Testing Session






